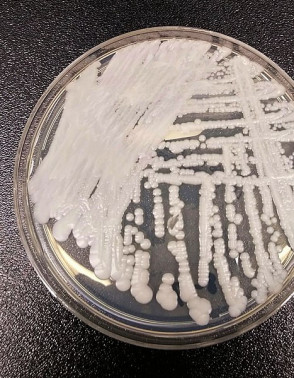

Candida auris: o que é e o que sabemos até agora sobre o 'superfungo'
O primeiro caso brasileiro de infecção pelo fungo foi identificado pela Anvisa na última segunda-feira, 7
Após a identificação de um possível caso de infecção pelo fungo Candida auris no Brasil, a Agência Nacional de Vigilância Sanitária (Anvisa) divulgou um alerta sobre o microorganismo. Até então, não havia relatos de nenhum caso brasileiro de infecção pelo 'superfungo' - um dos nomes pelo qual vem sendo referenciado desde a última segunda-feira, 7.
LEIA TAMBÉM | Camilo vai a SP para negociar aquisição da vacina contra a Covid-19 com Doria e Instituto Butantan
É + que streaming. É arte, cultura e história.
O comunicado da Anvisa traz informações sobre a identificação do caso, as problemáticas do fungo devido a sua alta resistência a medicamentos e informações de ação contra o microorganismo. Confira algumas informações sobre o Candida auris:
O que é o Candida auris?
É uma espécie de fungo identificada pela primeira vez como causador de doença em humanos em 2009. Desde então, as infecções pelo fungo emergente ocorrem em diversos países. Em um dos casos, identificado em Londres, o surto envolveu 22 pacientes adultos com infecções de corrente sanguínea, ferida cirúrgica e urinária, bem como 28 outros pacientes colonizados.
Até agora, pouco se sabe sobre o fungo. A identificação desse fungo requer métodos laboratoriais específicos uma vez que a Candida auris pode ser facilmente confundida com outras espécies de leveduras, tais como Candida haemulonii e Saccharomyces cerevisiae. Além disso, pode permanecer viável por longos períodos no ambiente (semanas ou meses) e apresenta resistência a diversos desinfetantes, entre os quais, os que são à base de quartenário de amônio.
Como e onde ele foi descoberto no Brasil?
A amostra foi coletada ainda na última sexta-feira, 4, na ponta do cateter de um paciente que está internado por complicações da Covid-19 na Unidade de Tratamento Intensivo (UTI) em um hospital na Bahia. A amostra foi encaminhada pelo laboratório do hospital ao Laboratório Central de Saúde Pública da Bahia (Lacen) e foi confirmada pelo Laboratório do Hospital das Clínicas da Faculdade de Medicina da Universidade de São Paulo (USP).
Na última segunda-feira, 7, o caso foi confirmado pela Anvisa. Ainda serão realizadas análises para verificar a resistência do fungo e o sequenciamento genético do microorganismo. Diante do caso, a Anvisa recomendou o reforço da vigilância laboratorial do fungo em todos os serviços de saúde do País, entre outras medidas de controle e prevenção para evitar um possível surto no País.
LEIA TAMBÉM | "Doença misteriosa" que atinge mais de 500 pessoa na Índia é causada por água contaminada
Ainda, uma equipe da Secretaria da Saúde do Estado da Bahia (Sesab) e da Secretaria Municipal da Saúde de Salvador averiguou o hospital e verifica se existe a contaminação de outras pessoas do serviço de saúde.
Quais seus riscos?
No comunicado, a Anvisa declara o Candida auris como "um fungo emergente que representa uma séria ameaça à saúde pública" e considera alguns pontos:
- o fungo apresenta resistência a vários medicamentos antifúngicos comumente usados para tratar infecções por Candida;
- pode causar infecção em corrente sanguínea e outras infecções invasivas, podendo ser fatal em pacientes com comorbidades, principalmente;
- pode permanecer nos ambientes por longos períodos e apresenta resistência a diversos desinfetantes;
- sua identificação requer métodos laboratoriais específicos, pois a Candida auris pode ser facilmente confundida com outras espécies de microorganismos do reino do fungos.
- ainda, devido ao seu difícil reconhecimento e eliminação do ambiente contaminado, há uma propensão em causar surtos.
Qual o histórico do Candida auris?
O fungo foi identificado pela primeira vez em 2009 no canal auditivo de uma paciente no Japão. Desde então, houve casos identificados em países como Índia, África do Sul, Venezuela, Colômbia, Estados Unidos, Israel, Paquistão, Quênia, Kuwait, Reino Unido e na Espanha.
Em outubro de 2016, a Organização Pan-Americana da Saúde (OPAS/OMS) publicou um alerta epidemiológico em função de surtos do fungo em serviços de saúde da América Latina. Em março de 2017, a Anvisa publicou um comunicado de risco contendo orientações para a vigilância e encaminhamento de isolados para o controle, em casos identificados de C. auris no Brasil. O primeiro caso no Brasil, entretanto, só foi confirmado em 2020.
Quais as recomendações para evitar a colonização do fungo?
Em comunicado emitido pela Anvisa em 2017, a agência informou que "o modo preciso de transmissão dentro do ambiente de saúde não é conhecido". As evidências seriam que o organismo pode se disseminar em ambientes médicos por contato com superfícies ou equipamentos contaminados ou de pessoa para pessoa. "No entanto, a experiência durante estes surtos sugere que C. auris pode contaminar substancialmente o ambiente de quartos de doentes colonizados ou infectados", informa o documento.
Ainda, "são considerados pacientes de risco para infecção por C. aurisaqueles internados em unidades de terapia intensiva por longos períodos, utilizando cateter venoso central e uso prévio de antibióticos ou antifúngicos", informou a agência.
Já no comunicado emitido em 2020, o reforço na vigilância para a identificação do Candida auris e limpeza constante de equipamentos médicos estão entre as recomendações emitidas pela Anvisa. Inclui, também, o informe de novos casos suspeitos à Comissão de Controle de Infecção Hospitalar (CCIH) do hospital no qual for relatado. A higienização constante das mãos também é uma medida contra a contaminação do fungo.
Dúvidas, Críticas e Sugestões? Fale com a gente

